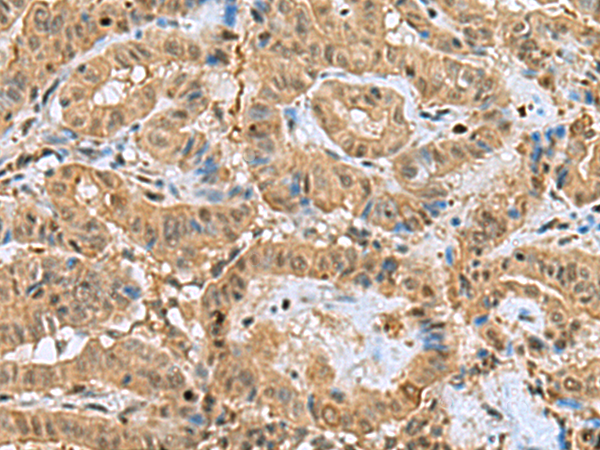
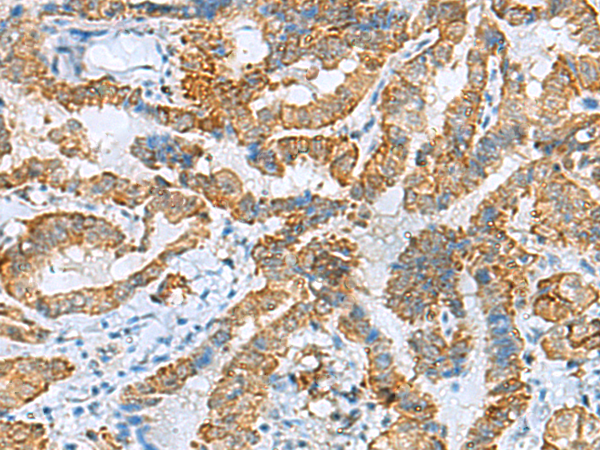

-
分类: 科研抗体货号: P03376别名: PP2A; PR53; PPP2R4应用: WB,IHC反应种属: Human, Mouse
-
分类: 科研抗体货号: P03284别名: IscS; NIFS; HUSSY-08应用: WB,IHC反应种属: Human, Mouse
-
分类: 科研抗体货号: P03373别名: FBS; DC10; FBX8应用: IHC反应种属: Human, Mouse
-
分类: 科研抗体货号: P03347别名: ANM; TNT; NEM5; STNT; TNTS应用: WB,IHC反应种属: Human, Mouse
-
分类: 科研抗体货号: P03372别名: RDH1; 9cRDH; SDR9C5; HSD17B9应用: IHC反应种属: Human, Mouse
-
分类: 科研抗体货号: P03342别名: CSEN; DREAM; KCHIP3应用: WB反应种属: Human, Mouse, Rat
-
分类: 科研抗体货号: P03369别名: MGL; HUK5; MAGL; HU-K5应用: WB反应种属: Human, Mouse, Rat
-
分类: 科研抗体货号: P03427别名: S31mt; IMOGN38; MRP-S31应用: IHC反应种属: Human
-
分类: 科研抗体货号: P03359别名: PhLP应用: WB,IHC反应种属: Human, Mouse, Rat
-
分类: 科研抗体货号: P03426别名: EBP1; HG4-1; p38-2G4应用: WB,IHC反应种属: Human, Mouse, Rat

鄂公网安备42018502007531号
鄂公网安备42018502007531号

